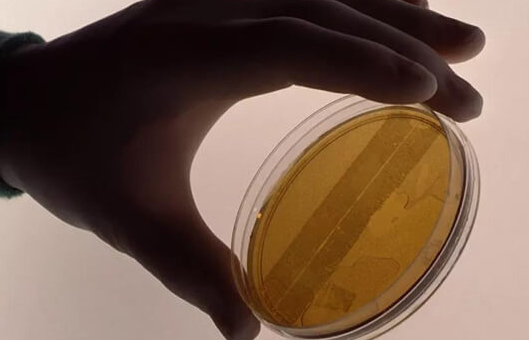

试管婴儿冻胚移植技术为众多不孕家庭带来了生育希望,其成功率受多重因素影响,其中女性年龄与子宫环境是最核心的两大要素。临床数据显示,冻胚移植整体成功率在40%-60%之间,但个体差异显著,年龄与子宫条件的优劣直接决定着受孕概率的高低。
一、年龄:成功率的核心分水岭
女性年龄是影响冻胚移植成功率的首要因素。卵巢功能随年龄增长呈断崖式下降,35岁后卵子质量与数量急剧减少,胚胎染色体异常率显著升高。数据显示,25-34岁女性冻胚移植成功率可达50%-60%,而35-39岁群体降至40%-50%,40岁以上则不足30%。例如,一位32岁女性因输卵管堵塞选择冻胚移植,其优质囊胚移植成功率可达65%;而同等情况的42岁女性,成功率可能不足25%。男性年龄增长同样影响精子质量,间接降低胚胎发育潜能。
二、子宫环境:胚胎着床的“土壤”
子宫是胚胎发育的“生命摇篮”,其环境优劣直接决定移植成败。子宫内膜厚度、形态与血流是关键指标:厚度达8-12mm、形态呈三线征、血流丰富的内膜最适宜胚胎着床。若内膜过薄(<7mm)或存在息肉、粘连等病变,成功率可能骤降至30%以下。例如,一位30岁女性因子宫内膜息肉导致两次移植失败,经宫腔镜手术切除息肉并调理内膜后,第三次移植成功受孕。此外,子宫畸形、腺肌症等疾病也会通过改变宫腔形态或引发炎症,显著降低妊娠率。
三、协同优化:提升成功率的关键策略
除年龄与子宫环境外,胚胎质量、内分泌水平及心理状态同样重要。优质囊胚(如玻璃化冷冻技术保存的胚胎)移植成功率比早期胚胎高15%-20%;移植前后激素水平稳定可维持内膜容受性;保持积极心态能减少皮质醇分泌,避免干扰胚胎着床。临床建议,高龄女性可优先选择PGT技术筛选染色体正常胚胎,子宫条件不佳者可通过中药调理、针灸改善血流,同时配合黄体支持治疗,多维度提升受孕概率。
冻胚移植的成功是年龄、子宫环境与医疗技术共同作用的结果。把握生育黄金期、积极改善子宫条件,是提高试管婴儿成功率的核心路径。






































